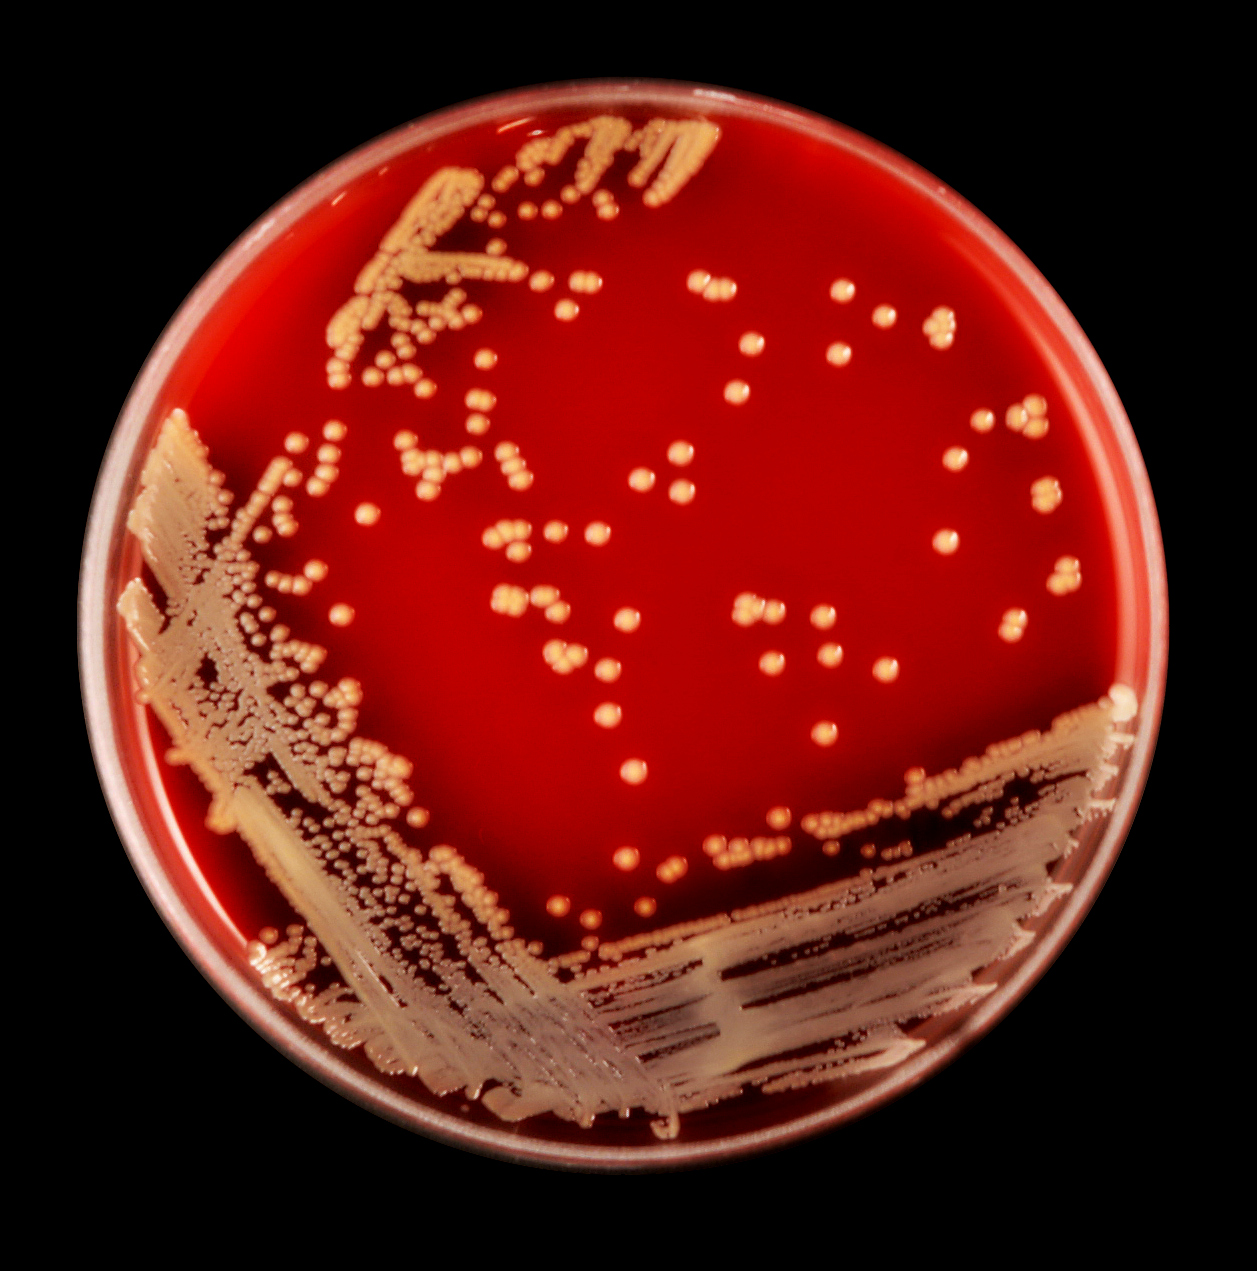

Staphylococcus pseudintermedius
Поставь машины помощь
Арташонов актер
Год аккумулятора топла
Rama beach hotel 4
Микрофон для караоке jbl
Клапана кпз
Соэ у мужчины что такое
Пирог на песочном тесте с заливкой
Мы были как вы
Вы здесь
Видео ракетных ударов сегодня
Почта на ленинском часы работы
Самокат tech отзывы
Staphylococcus pseudintermedius 99 фото